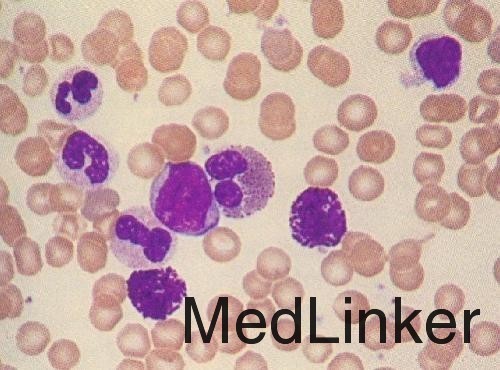

急性白血病误诊为风湿性关节炎
主诉 病史
患儿,男,4岁,因“发热2月,伴关节痛1月余”入院。患儿于2月前受凉后出现发热,最高39℃,伴乏力、食欲不振、多哭闹,曾于当地县级医院治疗,诊断为“上感”,并予抗感染治疗1周,病情无好转。于1月余前,患儿出现双下肢游走性关节疼痛,以踝关节和膝关节为甚,予阿司匹林、泼尼松治疗1月后,病情无明显缓解,为进 一步治疗遂来我院治疗。 自发病以来,患儿体重下降约5斤。既往体健,家族史无特殊。
查体 辅查
查体:体温38.7℃,中度贫血貌, 神清、皮肤无黄染及瘀斑瘀点,浅表淋巴结不大, 胸骨无压痛, 肝于右肋缘下 2cm处触及,脾未及。心肺(-)。右膝关节轻微肿胀、压痛、活动受限 。辅助检查:血常规示 HGB 67g/L,WBC 11x10^9,NE% 60%,YE% 29%,血小板计数85x10^9 /L 。外周血细胞涂片见较多的幼稚细胞。抗,“ O” >200U , 血沉125mm /h,C反应蛋白 ( +) , RF( -) 。尿粪常规、X线胸片、肝肾功能等未见明显异常。骨髓细胞涂片符合急性淋巴细胞性白血病L2型。
诊断 处理
诊断 : 急性淋巴细胞性白血病 L2型 。 治疗:予以化疗,现在为第四疗程。
随访 讨论
讨论:白血病原因是白血病细胞骨膜浸润 ,骨皮质 破坏以及白血病细胞过度增殖致骨髓腔压力增高等因素所致,因而抗风湿治疗无效 ,而化疗可使症状迅速缓解。以骨痛为首发症状的急性白血病, 早期易被误诊。本例患者在早期发生误诊的原因比较多,是以发热、游走性骨痛为首发表现,红细胞沉降率增快 , 抗链球菌溶血素 “ O”增高 , C反应蛋白 ( +) , 临床表现酷似风湿性关节炎。这提示临床以发热 、 大 关节游走性疼痛发病者应考虑到急性白血病的可能 , 必要时应作骨髓穿刺检查 , 以资鉴别。
发布于 15-10-20 21:47
